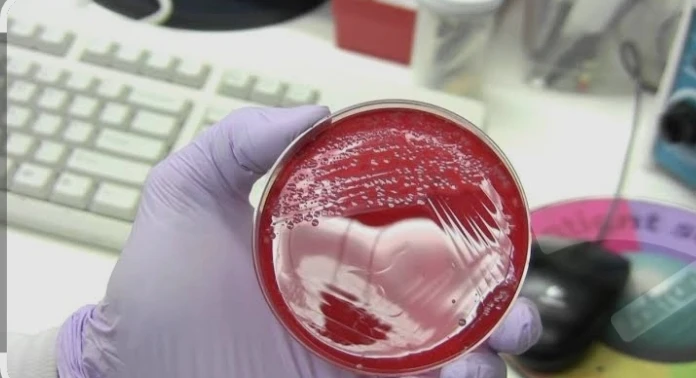
Culture & Sensitivity - Sputum

تفاصيل التحليل
مزرعة وحساسية البلغم
تحديد دقيق لنوع الميكروبات المسببة للسعال والبلغم والتهابات الرئة، مما يضمن اختيار المضاد الحيوي المناسب لعلاج العدوى الصدرية واستعادة كفاءة الجهاز التنفسي بسرعة.
الصورة التوضيحية المرتبطة بهذا التحليل